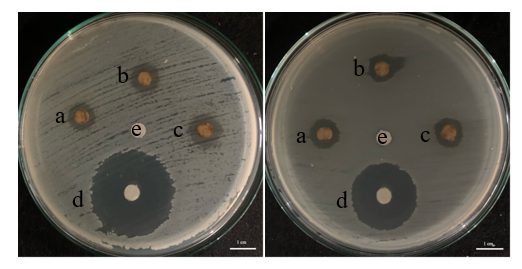

Trends
Sci.
2026; 23(1): 11324
Bioactive Compounds from Trentepohlia aurea as Potential Antibacterial Agents Targeting DNA Gyrase: An In Vitro and In Silico Approach
Oky Kusuma Atni, Erman Munir* and Nursahara Pasaribu
Department of Biology, Faculty of Mathematics and Natural Sciences, Universitas Sumatera Utara, Medan 20155, North Sumatera, Indonesia
(*Corresponding author’s e-mail: [email protected])
Received: 19 July 2025, Revised: 12 August 2025, Accepted: 19 August 2025, Published: 30 October 2025
Abstract
The global rise of antibiotic resistance underscores the urgent need for novel antibacterial agents with new mechanisms of action. Trentepohlia aurea, a carotenoid- and phenolic-rich subaerial green alga, remains largely unexplored for its therapeutic potential. This study evaluated the antibacterial activity of its methanol extract via in vitro disc diffusion assays and investigated the interaction of its bioactive constituents with bacterial DNA gyrase subunit B (PDB ID: 6KZZ) through in silico molecular docking. The extract produced inhibition zones of 11.3 ± 0.55 mm against Staphylococcus aureus, 10.9 ± 0.21 mm against Salmonella Typhii, and 10.8 ± 0.61 mm against Streptococcus mutans, indicating moderate antibacterial activity. GC-MS profiling identified 26 compounds, with Aphthosin exhibiting the strongest predicted gyrase-binding affinity (–7.4 kcal/mol), surpassing a native ligand. ADME-toxicity predictions suggested generally favorable pharmacokinetics with low toxicity, though some compounds displayed organ-specific risks. While MIC/MBC determinations and direct in vitro testing of individual compounds were not performed, this first report on T. aurea as a potential DNA gyrase inhibitor highlights its promise as a source of structurally diverse natural products for antibacterial drug discovery and warrants further mechanistic validation and potency optimization.
Keywords: Antibacterial, DNA gyrase, GC-MS, In silico, Molecular docking, Trentepohlia aurea
Introduction
Algae comprise a vast array of photosynthetic organisms, varying from unicellular microscopic species to large multicellular forms, encompassing both prokaryotic and eukaryotic types 1,2 . Algal organisms are prolific producers of structure ally unique and physiologically active compounds. A multitude of alleged bioactive compounds produced by these organisms as primary or secondary metabolites has attracted attention in the pharmaceutical sector 3 . Microalgal metabolism adapts to alterations in the external environment by modifying its internal conditions. Consequently, altering the cultural conditions or the availability of nutrients enhances the synthesis of specific compounds. Several research have been done to explore the products of microalgal metabolism, not only to better understand their nature, but also to look for chemicals with potential human
applications in a variety of disciplines. Extracts or metabolites from various microalgae are commonly screened to determine their biological activity. Microalgae have been recognized as abundant suppliers of numerous bio compounds with economic interest [4-6].
The family Trentepohliaceae and order Trentepohliales include Trentepohlia. The Ulvophyceae class of Chlorophyta includes this subaerial algae genus. Trentepohlia is the most abundant tropical and subtropical subaerial algae [7]. The diversity of Trentepohlia species is influenced by altitude and environmental factors, including humidity, temperature, and light intensity [8]. Trentepohlia species synthesize substantial quantities of carotenoids that provide protection against ultraviolet radiation and elevated irradiance. Their pigments give them a distinguishable yellow, orange, or red color in natural settings [9]. Important bioactive substances identified in the genus Trentepohlia include β-carotene, lutein, astaxanthin, microalgal pigments such as chlorophylls (a, b and c), phycocyanin, phycoerythrin, β-carotene, and phycobiliproteins [10]. Trentepohlia holds significant potential as a valuable resource in the pharmaceutical sector, particularly for its antimicrobial and antioxidant properties. Its bioactive compounds can be utilized to develop new antimicrobial agents to combat infections and antioxidants to protect against oxidative stress, thereby contributing to advancements in therapeutic and preventive healthcare solutions [11,12].
Schema of the PDB The DNA gyrase B complex with a 2-oxo-1,2-dihydroquinoline derivative is seen in the crystal structure of Escherichia coli at 6KZZ. One of the most important enzymes for DNA replication and transcription is DNA gyrase, which is produced by bacteria. It adds negative supercoils into DNA [13]. The 2 components of DNA gyrase, GyrA and GyrB, work together as a heterodimer. DNA cleavage and rejoining are carried out by GyrA, whereas the energy required for these processes is supplied by GyrB, which displays ATPase activity [14,15]. The GyrB subunit is targeted by many antibacterial agents due to its role in ATP hydrolysis. Competing in ATP GyrB inhibitors are made up of different chemical groups, such as coumarins, arylaminopyrimidines, ethyl ureas, tricyclic inhibitors, and pyrrolamides. They are good at killing both Gram-positive and Gram-negative bacteria [16]. The 6KZZ structure provides significant insights into the binding interactions and mechanisms of these inhibitors. Comprehending this structural information is essential for clarifying the impact of these compounds on DNA gyrase function, thereby facilitating the creation of novel antimicrobial agents and strategies to address bacterial resistance. Remarkably, metabolites derived from algae, such as those from T. aurea, have demonstrated the ability to inhibit DNA gyrase similarly to synthetic antibiotics. This provides new ways to improve treatment efficacy against resistant bacterial strains and emphasizes the possibility of chemicals derived from algae as natural alternatives to tackle the increasing problem of bacterial resistance.
Materials and methods
Preparation of the Trentepohlia aurea extracts
Trentepohlia aurea (Linnaeus) C. Martius, obtained from Bukit Barisan Grand Forest Park, North Sumatra, Indonesia, was initially cleaned and desiccated. The samples were desiccated in an oven (UN 55 Universal Oven, Memmert, Germany) at 35 °C for 4 - 5 days to eliminate residual moisture. The desiccated algal substance was subsequently pulverized into a fine powder utilizing a blender. Extraction was conducted via the maceration method utilizing 70% methanol for 3 successive cycles, each lasting 24 h, at ambient temperature on a shaker operating at 150 rpm. Following each cycle, the filtrate was extracted from the residue utilizing filter paper. The amalgamated filtrates were concentrated with a rotary evaporator to yield a viscous extract. Using Dimethyl Sulfoxide (DMSO) as the solvent, the concentrated extract was further diluted until it reached a final concentration of 50%. The crude extract yield was 2.78 g, corresponding to 2.78 %(w/w) of the initial dry biomass. No standardization or quantification of total phenolic, flavonoid, or carotenoid content was performed in this study, which is acknowledged as a limitation in interpreting the bioactivity results.
Antibacterial assays of Trentepohlia aurea extracts
Pathogens used for antibacterial activity
In this study, we employed 3 Gram-positive bacterial strains: Staphylococcus aureus ATCC 6538, Propionibacterium acnes ATCC 6919, and Streptococcus mutans ATCC 35668, alongside 3 Gram-negative strains: Salmonella enterica serovar Typhii IPBCC b 11 669, Escherichia coli ATCC 8739, and Pseudomonas aeruginosa ATCC 15442, to evaluate their antimicrobial activity.
Antibacterial activity
The evaluation of antibacterial efficacy was conducted using the disc diffusion method [17-19]. Twenty mL of Mueller-Hinton Agar (MHA) medium was dispensed into sterile Petri dishes and allowed to solidify. A bacterial suspension, adjusted to the turbidity of a 0.5 McFarland standard, was uniformly spread across the agar surface using a sterile cotton swab. Sterile 6 mm discs were impregnated with 100 µL of a 50% methanolic extract of T. aurea and placed onto the inoculated agar. Chloramphenicol served as the positive control and dimethyl sulfoxide (DMSO) as the negative control. The plates were incubated at room temperature for 24 h, and antibacterial activity was determined by measuring the inhibition zone diameters.
A 1 μL volume of the filtered sample, obtained via a membrane filter, was injected into a Shimadzu GCMS-QP2010 Plus for volatile component profiling. Prior to injection, the crude 70% methanol extract obtained by maceration was concentrated and diluted using 2 mL of HPLC-grade methanol (99.5%). No derivatization was performed. The prepared sample was injected using a split ratio of 1:1 through a split-splitless injector maintained at 250 °C, with the mass spectrometer detector temperature set at 280 °C. Separation was achieved on a Restek Rtx®-50 column (Crossbond® 5% phenyl-50% methyl polysiloxane, 30 m×0.25 mm i.d., 0.25 μm film thickness). Helium was used as the carrier gas at 64.1 kPa, with a total flow of 4.9 mL/min, column flow of 0.99 mL/min, linear velocity of 36.6 cm/s, and purge flow of 3.0 mL/min. The oven temperature was programmed from 80 °C (held for 2 min) to 280 °C (held for 8 min). Peak identification was performed using the Wiley9.LIB and cross-validated with the NIST17 library, with a minimum similarity index (SI) threshold of 70 - 80 to confirm compound matches. Compound assignments were based on an internal method following established GC-MS identification criteria. Although the analysis was conducted on a crude methanol extract without preliminary fractionation, this approach was selected to capture the full spectrum of volatile and semi-volatile constituents present in the extract, in line with previous studies reporting reliable bioactive compound detection under similar conditions [18,19].
Protein-ligan preparation
The bioactive compounds from T. aurea used in this study are: Here is a paragraph that includes the compound names with their respective PubChem IDs: Morpholine, 2,6-dimethyl-4-tridecyl- (32518), Carbamic acid, monoammonium salt (517232), Oxiranemethanol (11164), Hexanal (6184), Heptanal (8130), Dianhydroglucitol, tbs 2x, Cyclohexanone, 2,2,6-trimethyl- (17000), 2 octenal (5283324), Cyclopentanone, 2-methyl-3-(1-methylethyl)- (41124), 1-methylcycloheptanol (77376), 1,2,3-propanetriol (753), 2-decenal, (e)- (5283345), 6-methyl-6-nitro-2-heptanone (537587), Isosorbide (12597), (2,2,6,6-tetramethylcyclohexylidene) methanone, 2-Benzofuranmethanol, 2,4,5,6,7,7a-hexahydro-4,4,7a-trimethyl-, cis- (21578471), Phenol, 2,6-dimethoxy- (7041), Trans-. Beta. -ionon-5,6-epoxide, 8-hydroxygeraniol (5363397), 2(4H)-Benzofuranone, 5,6,7,7a-tetrahydro-4,4,7a-trimethyl- (27209), 1,2,3,4-tetrahydroxybutane (8998), Tetradecanoic acid (11005), Hexadecanoic acid, methyl ester (8181), Aphthosin (15595748), Hexadecanoic acid (985), 10,13-Eicosadienoic acid, methyl ester (5365687). Furthermore, the compound 4-[[8-(methylamino)-2-oxidanylidene-1~{H}-quinolin-3-yl]carbonylamino]benzoic acid9 (Control) (PubChem CID:) was employed as a reference control chemical to evaluate the inhibitory properties of the bioactive compounds obtained from T. aurea. The 2D and 3D structures of the active ingredients found in T. aurea and the control were acquired from the appropriate chemical databases on PubChem. Subsequently, these structures were optimized for energy and transformed into the .pdb file format using Open Babel in PyRx software.
Biological activities prediction using the PASS online
The biological activity prediction of the bioactive compounds from T. aurea was performed using the Prediction of Activity Spectra for Substances (PASS) server on the Way2drug platform (http://way2drug.com/PassOnline/). The SMILES structures of each GC-MS-identified compound were retrieved from the PubChem database (http://pubchem.ncbi.nlm.nih.gov) and submitted individually to the PASS Online server. The prediction results provided probability of activity (Pa) and inactivity (Pi) values for various biological functions. In this study, a Pa value > 0.70 was considered to indicate high potential biological activity, 0.50 ≤ Pa ≤ 0.70 indicated moderate activity, and Pa < 0.50 suggested low activity. Twenty-two compounds with available SMILES data were evaluated, with details presented in Table 2. The combination of high Pa values and low Pi values was used to prioritize compounds for further docking and ADME-toxicity analyses.
Lipinski’s rule of 5 was utilized to assess the degree to which the compounds mimicked the properties of drugs. All the compounds were evaluated using SwissADME (http://www.swissadme.ch/), which is a drug-likeness evaluation framework. The number of hydrogen bond acceptors and donors, the molecular weight, and the bioavailability of the molecule are some of the parameters that are included in this resource. It is possible to determine the oral bioavailability of a compound with the help of Lipinski’s rule of 5.
Pharmacokinetics predictions
Pharmacokinetics predictions were evaluated by assessing each compound’s ability to penetrate the blood-brain barrier (BBB) using the pkcSM webserver (http://biosig.lab.uq.edu.au/pkcsm/prediction). Additionally, both BBB permeability and human intestinal absorption (HIA) patterns were analyzed using the BOILED-Egg predictive model.
Molecular docking analysis
Molecular docking was performed to evaluate the binding affinities of the identified compounds toward DNA Gyrase subunit B (PDB ID: 6KZZ). Protein and ligand preparations were conducted using BIOVIA Discovery Studio 2024 for visualization, removal of water molecules and co-crystallized ligands, and the addition of polar hydrogen atoms when necessary. Ligand structures were retrieved from the PubChem database (http://pubchem.ncbi.nlm.nih.gov) in .sdf format, optimized, and converted into .pdbqt format using Open Babel integrated in PyRx v.0.8. DNA Gyrase was selected as it plays a crucial role in bacterial DNA replication and is a well-established target for antibacterial drug development.
Docking simulations were carried out using AutoDock Vina within PyRx 8.0.0, treating the protein as the macromolecule and the bioactive compounds as ligands. The docking grid box was set with center coordinates at (1.3057×1.4901×0.3121) and dimensions of (36.7569×19.5379×18.1727 Å3) to encompass the active site. Binding affinity values (kcal/mol) were used to rank ligand–protein interactions, and the interaction profiles were analyzed to identify hydrogen bonds, hydrophobic interactions, and electrostatic contacts. Visualization and identification of key amino acid residues at the binding site were performed using both PyMOL and BIOVIA Discovery Studio 2024.
T. aurea morphology
T. aurea, a terrestrial filamentous green alga gathered in Bukit Barisan Grand Forest Park, North Sumatra, Indonesia, as illustrated in Figure 1, is a cosmopolitan species with an extensive distribution range. This wide distribution highlights its strong ecological adaptability and ability to occupy diverse ecological niche.
Trentepohlia aurea (L.) C.F.P. Martius, Family: Ulvophyceae. Filamentous form: Fine filaments growing upright in very large numbers, capable of covering extensive surfaces in golden-yellow, yellow-orange, and orange colors. Habitat: Humid, shaded environments, adhering to tree bark, rocks, and moist cement walls. Distribution: Widespread throughout the study area at altitudes ranging from 867 to 978 masl. Characterized by carotenoid pigments that mask green chlorophyll and contribute to its striking yellow-orange coloration. This green alga often symbiotically associates with lichenized fungi, acting as a photobiont in such cases. Identification was based solely on morphological characteristics following relevant taxonomic keys, without voucher specimen deposition or molecular confirmation, which is acknowledged as a limitation given the morphological similarity among members of the order Trentepohliales.

Figure 1 Morphology of T. aurea: (A) Trees covered with massive growth of T. aurea; (B) Population of T. aurea on the tree bark; (C) T. aurea filaments observed under 100× magnification; (D) Carotenoid pigments in T. aurea filaments observed under 400× magnification. (C) and (D) were captured using an Olympus CX43 microscope equipped with a DP75 camera and CellSens Dimensions software.
Antimicrobial activity Trentepohlia aurea
The subsequent table displays the outcomes of antimicrobial activity assays utilizing methanol extracts of T. aurea, assessed against various pathogenic microorganisms. Chloramphenicol (10 µg/disk) was used as a standard antibiotic positive control, and DMSO as a negative control, to enable comparison of the extract’s relative efficacy. Table 1 presents the results of antimicrobial activity testing utilizing methanol extract from T. aurea algae against diverse pathogenic microorganisms. The highest activity is observed against S. aureus, a Gram-positive bacterium, with an inhibition zone 11.3 ± 0.55 mm. Additionally, the methanol extract also exhibits significant antimicrobial activity against S. enterica serovar Typhii 10.9 ± 0.21 mm (Figure 2) and S. mutans 10.8 ± 0.61 mm. However, lower activity is observed against E. coli and P. aeruginosa with inhibition zone 10.0 ± 1.22 mm and 9.8 ± 0.70 mm, respectively. The data suggest that the methanol extract from T. aurea possesses potential as an antimicrobial agent against various bacteria, particularly exhibiting the highest efficacy against Gram-positive bacteria like S. aureus.
Table 1 Antimicrobial efficacy of methanol extract from aerial microalgae T. aurea.
Microorganism |
Inhibition zone (mm) |
||
Methanol extract algae (10 µL/disk) |
Chloramphenicol |
||
Gram-Negative Bacteria |
S. enterica serovar Typhii IPBCC b 11 669 |
10.9 ± 0.21 |
25.2 ± 0.5 |
E. coli ATCC 8739 |
10.0 ± 1.22 |
24.9 ± 1.7 |
|
P. aeruginosa ATCC 15442 |
9.8 ± 0.70 |
28.7 ± 1.8 |
|
Gram-Positive Bacteria |
S. aureus ATCC 6538 |
11.3 ± 0.55 |
31.1 ± 1.5 |
P. acnes ATCC 6919 |
- |
14.8 ± 1.0 |
|
S. mutans ATCC 35668 |
10.8 ± 0.61 |
27.1 ± 0.4 |
|
The green alga Trentepohlia umbrina has been previously studied for antimicrobial activity by Simic et al. 20 , whereas studies on the antimicrobial activity of T. aurea are currently being investigated for the first time. Consistent with results from studies on other algae, we observed that the methanol extract of T. aurea exhibited relatively strong antimicrobial activity, more so than Gram-negative bacteria, especially when it comes to Gram-positive bacteria. These differences in antimicrobial activity are attributed to variations in the cell walls of both gram-positive and gram-negative bacteria. Gram-negative bacteria feature 2 lipid membranes with peptidoglycan and lipopolysaccharides (LPS), along with a periplasmic space containing degrading enzymes 21 . The cell walls of Gram-positive bacteria are thick and made of cross-linked peptidoglycan. They also have a single lipid membrane. The structural differences between Gram-positive and Gram-negative bacteria explain why antibacterial agents are more effective against the former 22 .
In addition, carotenoids, including β-carotene, are key compounds found in T. aurea, contributing to its hues ranging from golden-yellow to orange tones [23]. Although research on the antibacterial properties of microalgal β-carotene is limited, recent findings by Jaber and Majeed [24], highlight its potent β-carotene antibacterial activity against various bacteria, particularly Gram-positive strains. These results emphasize β-carotene’s potential as a promising antimicrobial agent.
![]()
Figure 2 Inhibition zones of methanol extract of T. aurea against bacteria: (A) Gram-positive bacteria S. aureus (a) - (c). Replicates of methanol extract of T. aurea; (d) Positive control (Chloramphenicol); (e) Negative control (Dimethyl sulfoxide)), and (B) Gram-negative bacteria S. enterica serovar Typhii (a) - (c). Replicates of methanol extract of T. aurea; (d) Positive control (Chloramphenicol); (e) Negative control (Dimethyl sulfoxide).
Gas chromatograpy-mass spectrometry analysis
Raw data from GC-MS and individual chromatograms were processed using Origin software. The GC-MS analysis revealed 26 bioactive compounds in T. aurea. These compounds include Morpholine, 2,6-dimethyl-4-tridecyl-, Carbamic acid, monoammonium salt, Oxiranemethanol, Hexanal, Heptanal, Dianhydroglucitol, tbs 2x, Cyclohexanone, 2,2,6-trimethyl-, 2 octenal, Cyclopentanone, 2-methyl-3-(1-methylethyl)-, 1-methylcycloheptanol, 1,2,3-propanetriol, 2-decenal, (e)-, 6-methyl-6-nitro-2-heptanone, Isosorbide, (2,2,6,6-tetramethylcyclohexylidene) methanone, 2-Benzofuranmethanol, 2,4,5,6,7,7a-hexahydro-4,4,7a-trimethyl-, cis-, Phenol, 2,6-dimethoxy-, Trans-. Beta. -ionon-5,6-epoxide, 8-hydroxygeraniol, 2(4H)-Benzofuranone, 5,6,7,7a-tetrahydro-4,4,7a-trimethyl-, 1,2,3,4-tetrahydroxybutane, Tetradecanoic acid, Hexadecanoic acid, methyl ester, Aphthosin, Hexadecanoic acid, 10,13-Eicosadienoic acid, methyl ester. Retention times are presented in Table 2, and the chromatogram is depicted in Figure 3. Based on a screening in PubChem, certain compounds do not possess available 3D structures; therefore, 22 of these compounds catalogued in the database will be employed for docking analysis.

Figure 3 GC-MS Chromatogram of T. Aurea.
Table 2 Compounds of T. aurea (linnaeus) C. martius.
No |
Compound name |
Mol. Formula |
Mass (g/mol) |
R. Time (min) |
Smiles |
PubChem CID |
1 |
Morpholine, 2,6-dimethyl-4-tridecyl- |
C19H39NO |
297 |
0.076 |
CCCCCCCCCCCCCN1CC(OC(C1)C)C |
32518 |
2 |
Carbamic acid, monoammonium salt |
CH3NO2 |
61 |
1.775 |
C(=O)(N)[O−]·[NH4+] |
517232 |
3 |
Oxiranemethanol |
C3H6O2 |
74 |
3.548 |
C1C(O1)CO |
11164 |
4 |
Hexanal |
C6H12O |
100 |
4.325 |
CCCCCC=O |
6184 |
5 |
Heptanal |
C7H14O |
114 |
6.104 |
CCCCCCC=O |
8130 |
6 |
Dianhydroglucitol, tbs 2x |
C12H24O2 |
200 |
8.742 |
|
|
7 |
Cyclohexanone, 2,2,6-trimethyl- |
C9H16O |
140 |
9.99 |
CC1CCCC(C1=O)(C)C |
17000 |
8 |
2 octenal |
C8H14O |
126 |
10.864 |
CCCCCC=CC=O |
5283324 |
9 |
Cyclopentanone, 2-methyl-3-(1-methylethyl)- |
C9H16O |
140 |
2.083 |
CC1C(CCC1=O)C(C)C |
41124 |
10 |
1-methylcycloheptanol |
C8H16O |
128 |
3.002 |
CC1(CCCCCC1)O |
77376 |
11 |
1,2,3-propanetriol |
C3H8O3 |
92 |
15.341 |
C(C(CO)O)O |
753 |
12 |
2-decenal, (e)- |
C10H18O |
154 |
16.598 |
CCCCCCCC=CC=O |
5283345 |
13 |
6-methyl-6-nitro-2-heptanone |
C8H15NO3 |
173 |
18.432 |
CC(=O)CCCC(C)(C)[N+](=O)[O−] |
537587 |
14 |
Isosorbide |
C6H10O4 |
146 |
19.256 |
C1C(C2C(O1)C(CO2)O)O |
12597 |
15 |
(2,2,6,6-tetramethylcyclohexylidene) methanone |
C11H18O |
166 |
19.976 |
|
349282968 |
16 |
2-Benzofuranmethanol, 2,4,5,6,7,7a-hexahydro-4,4,7a-trimethyl-, cis- |
C12H20O2 |
196 |
21.554 |
CC1(CCCC2(C1=CC(O2)CO)C)C |
21578471 |
17 |
Phenol, 2,6-dimethoxy- |
C8H10O3 |
154 |
22.342 |
COC1=C(C(=CC=C1)OC)O |
7041 |
18 |
Trans-. Beta. -ionon-5,6-epoxide |
C13H20O2 |
208 |
23.345 |
|
|
19 |
8-hydroxygeraniol |
C10H18O2 |
170 |
25.081 |
CC(=CCO)CCC=C(C)CO |
5363397 |
20 |
2(4H)-Benzofuranone, 5,6,7,7a-tetrahydro-4,4,7a-trimethyl- |
C11H16O2 |
180 |
27.275 |
CC1(CCCC2(C1=CC(=O)O2)C)C |
27209 |
21 |
1,2,3,4-tetrahydroxybutane |
C4H10O4 |
122 |
29.523 |
C(C(C(CO)O)O)O |
8998 |
22 |
Tetradecanoic acid |
C14H28O2 |
228 |
30.578 |
CCCCCCCCCCCCCC(=O)O |
11005 |
23 |
Hexadecanoic acid, methyl ester |
C17H34O2 |
270 |
31.353 |
CCCCCCCCCCCCCCCC(=O)OC |
8181 |
24 |
Aphthosin |
C34H30O13 |
646 |
32.984 |
CC1=CC(=CC(=C1C(=O)OC2=CC(=C(C(=C2)C)C(=O)OC3=CC(=C(C(=C3)C)C(=O)OC4=CC(=C(C(=C4)C)C(=O)OC)O)O)O)O)OC |
15595748 |
25 |
Hexadecanoic acid |
C16H32O2 |
256 |
34.633 |
CCCCCCCCCCCCCCCC(=O)O |
985 |
26 |
10,13-Eicosadienoic acid, methyl ester |
C21H38O2 |
322 |
35.202 |
CCCCCCC=CCC=CCCCCCCCCC(=O)OC |
5365687 |
Prediction of compound biological activities
The predicted antimicrobial potential of various compounds from T. aurea, based on their inhibition of key microbial targets, is presented in Table 3. For instance, Morpholine, 2,6-dimethyl-4-tridecyl- shows high activity as a membrane integrity antagonist (Pa = 0.886, Pi = 0.003) and sphinganine kinase inhibitor (Pa = 0.789, Pi = 0.015), both of which can disrupt microbial cell functions. Oxiranemethanol exhibits relatively strong inhibitory potential against glucan endo-1,3-beta-D-glucosidase (Pa = 0.940, Pi = 0.002) and saccharopepsin (Pa = 0.960, Pi = 0.002), which are crucial for microbial cell wall and protein synthesis. Tetradecanoic acid has high inhibitory activity against saccharopepsin (Pa = 0.961, Pi = 0.002) and glucan endo-1,3-beta-D-glucosidase (Pa = 0.945, Pi = 0.002). Similarly, Hexadecanoic acid, methyl ester shows relatively strong potential as a saccharopepsin inhibitor (Pa = 0.962, Pi = 0.002) and chymosin inhibitor (Pa = 0.962, Pi = 0.002). Heptanal is predicted to inhibit exoribonuclease II (Pa = 0.846, Pi = 0.004) and chymosin (Pa = 0.909, Pi = 0.004), while 2-Decenal, (E)- is shown to be an antieczematic agent (Pa = 0.903, Pi = 0.005) and TRPA1 agonist (Pa = 0.705, Pi = 0.002), potentially disrupting microbial integrity. The elevated Pa and diminished Pi values suggest a significant probability of antimicrobial effectiveness, rendering these compounds viable candidates for additional investigation in antimicrobial drug development.
Table 3 Prediction biological activity compounds of T. aurea.
No |
Compound name |
Biological activity |
Pa |
Pi |
Criteria |
1 |
Morpholine, 2,6-dimethyl-4-tridecyl- (CAS) |
Membrane integrity antagonist |
0.886 |
0.003 |
High |
Polyporopepsin inhibitor |
0.789 |
0.022 |
High |
||
Sphinganine kinase inhibitor |
0.789 |
0.015 |
High |
||
2 |
Carbamic acid, monoammonium salt (CAS) |
- |
- |
- |
- |
3 |
Oxiranemethanol (CAS) |
Glucan endo-1,3-beta-D-glucosidase inhibitor |
0.940 |
0.002 |
High |
Alkenylglycerophosphocholine hydrolase inhibitor |
0.924 |
0.004 |
High |
||
Saccharopepsin inhibitor |
0.960 |
0.002 |
High |
||
Polyporopepsin inhibitor |
0.939 |
0.003 |
High |
||
4 |
Hexanal (CAS) |
Glucan 1,4-alpha-maltotriohydrolase inhibitor |
0.880 |
0.002 |
High |
Cyclomaltodextrinase inhibitor |
0.891 |
0.002 |
High |
||
Antiseptic |
0.718 |
0.005 |
High |
||
Alkenylglycerophosphocholine hydrolase inhibitor |
0.876 |
0.008 |
High |
||
5 |
Heptanal (CAS) |
Exoribonuclease II inhibitor |
0.846 |
0.004 |
High |
Chymosin inhibitor |
0.909 |
0.004 |
High |
||
Polyporopepsin inhibitor |
0.940 |
0.003 |
High |
||
Acrocylindropepsin inhibitor |
0.909 |
0.004 |
High |
||
6 |
Cyclohexanone, 2,2,6-trimethyl- (CAS) |
Antieczematic |
0.788 |
0.021 |
High |
Membrane permeability inhibitor |
0.705 |
0.037 |
|
||
Antiseborrheic |
0.760 |
0.026 |
High |
||
7 |
2 OCTENAL |
Chymosin inhibitor |
0.866 |
0.009 |
High |
Saccharopepsin inhibitor |
0.866 |
0.009 |
High |
||
Cutinase inhibitor |
0.810 |
0.005 |
High |
||
Fusarinine-C ornithinesterase inhibitor |
0.700 |
0.023 |
High |
||
8 |
Cyclopentanone, 2-methyl-3-(1-methylethyl)- (CAS) |
Antieczematic |
0.887 |
0.005 |
High |
Membrane permeability inhibitor |
0.774 |
0.015 |
High |
||
Antiseborrheic |
0.704 |
0.037 |
High |
||
9 |
1-Methylcycloheptanol |
Membrane integrity agonist |
0.903 |
0.010 |
High |
Antiseborrheic |
0.884 |
0.005 |
High |
||
NADPH peroxidase inhibitor |
0.787 |
0.014 |
High |
||
10 |
1,2,3-Propanetriol (CAS) |
Membrane integrity agonist |
0.945 |
0.004 |
High |
Saccharopepsin inhibitor |
0.915 |
0.004 |
High |
||
Chymosin inhibitor |
0.915 |
0.004 |
High |
||
11 |
2-Decenal, (E)- (CAS) |
Glutamyl endopeptidase II inhibitor |
0.720 |
0.023 |
High |
TRPA1 agonist |
0.705 |
0.002 |
High |
||
Antieczematic |
0.903 |
0.005 |
High |
||
12 |
6-methyl-6-nitro-2-heptanone |
Gluconate 2-dehydrogenase (acceptor) inhibitor |
0.933 |
0.003 |
High |
Saccharopepsin inhibitor |
0.861 |
0.010 |
High |
||
Acrocylindropepsin inhibitor |
0.861 |
0.010 |
High |
||
Chymosin inhibitor |
0.861 |
0.010 |
High |
||
13 |
Isosorbide |
Pectate Lyase Inhibitor |
0.700 |
0.005 |
High |
Polyporopepsin inhibitor |
0.756 |
0.028 |
High |
||
Manganese peroxidase inhibitor |
0.789 |
0.005 |
High |
||
14 |
2-Benzofuranmethanol, 2,4,5,6,7,7a-hexahydro-4,4,7a-trimethyl-, cis- (CAS) |
Antieczematic |
0.748 |
0.031 |
High |
Glucan endo-1,6-beta-glucosidase inhibitor |
0.731 |
0.015 |
High |
||
UDP-N-acetylglucosamine 4-epimerase inhibitor |
0.710 |
0.015 |
High |
||
15 |
Phenol, 2,6-dimethoxy- (CAS) |
Membrane integrity agonist |
0.901 |
0.011 |
High |
Antiseborrheic |
0.876 |
0.006 |
High |
||
Saccharopepsin inhibitor |
0.850 |
0.011 |
High |
||
Acrocylindropepsin inhibitor |
0.850 |
0.011 |
High |
||
16 |
8-hydroxygeraniol |
Retinol dehydrogenase inhibitor |
0.940 |
0.000 |
High |
Undecaprenyl-phosphate mannosyltransferase inhibitor |
0.938 |
0.001 |
High |
||
Membrane integrity agonist |
0.793 |
0.038 |
High |
||
17 |
2(4H)-Benzofuranone, 5,6,7,7a-tetrahydro-4,4,7a-trimethyl- (CAS) |
General pump inhibitor |
0.744 |
0.005 |
High |
CYP2J substrate |
0.807 |
0.019 |
High |
||
Antieczematic |
0.791 |
0.020 |
High |
||
18 |
1,2,3,4-Tetrahydroxybutane |
Macrophage stimulant |
0.926 |
0.001 |
High |
Beta-mannosidase inhibitor |
0.927 |
0.001 |
High |
||
Mannose isomerase inhibitor |
0.826 |
0.001 |
High |
||
19 |
Tetradecanoic acid (CAS) |
Acrocylindropepsin inhibitor |
0.961 |
0.002 |
High |
Saccharopepsin inhibitor |
0.961 |
0.002 |
High |
||
Glucan endo-1,3-beta-D-glucosidase inhibitor |
0.945 |
0.002 |
High |
||
20 |
Hexadecanoic acid, methyl ester (CAS) |
Saccharopepsin inhibitor |
0.962 |
0.002 |
High |
Acrocylindropepsin inhibitor |
0.942 |
0.003 |
High |
||
Chymosin inhibitor |
0.962 |
0.002 |
High |
||
Acylcarnitine hydrolase inhibitor |
0.942 |
0.003 |
High |
||
21 |
Aphthosin |
Antiseptic |
0.852 |
0.004 |
High |
Antifungal |
0.500 |
0.030 |
Low |
||
Membrane integrity agonist |
0.881 |
0.016 |
High |
||
22 |
Hexadecanoic acid (CAS) |
Saccharopepsin inhibitor |
0.961 |
0.002 |
High |
Chymosin inhibitor |
0.961 |
0.002 |
High |
||
CYP2J substrate |
0.962 |
0.002 |
High |
||
Acrocylindropepsin inhibitor |
0.961 |
0.002 |
High |
Prediction of drug-likeness
According to Lipinski’s rule of 5, which assesses a compound’s drug-likeness based on molecular weight (MW ≤ 500), lipophilicity (MlogP ≤ 4.15), number of hydrogen bond donors (NHorOH ≤ 5), and acceptors (NorO ≤ 10), Table 4 lists the physicochemical properties of different compounds from T. aurea. Compounds like Carbamic acid, monoammonium salt (MW = 61, MlogP = −6.14, 0 violations), Oxiranemethanol (MW = 74, MlogP = −1.03, 0 violations), Hexanal (MW = 100, MlogP = 1.39, 0 violations), Heptanal (MW = 114, MlogP = 1.74, 0 violations), and 1,2,3-Propanetriol (MW = 92, MlogP = −1.51, 0 violations) show no violations, indicating good drug-like properties and potential oral bioavailability. Others, such as Hexadecanoic acid, methyl ester (MW = 270, MlogP = 4.44, 1 violation) and Hexadecanoic acid (MW = 256, MlogP = 4.19, 1 violation) have slightly higher lipophilicity, leading to one violation, which could affect their absorption or permeability. Aphthosin (MW = 646, MlogP = 2.83, 2 violations) has a high molecular weight and multiple hydrogen bond acceptors, suggesting it may have poor absorption and limited oral bioavailability. Overall, most compounds adhere to Lipinski’s criteria, indicating favorable pharmacokinetic properties, making them promising candidates for further drug development research.
To estimate the likelihood that a chemical molecule with a given pharmacological or biological action will have an oral effect on humans, the Rule of Five (ROF) is used as a general guideline [25]. The ROF rating for an orally active medicine ranges from “0” to “4”, indicating no more than one violation of the exposed criterion. Lipinski cautions against dismissing these molecules entirely, as many medicines do not undergo ROF [26]. Although the rule of 5 has a broad application, there are certain flaws. The 2 key drawbacks are the equal weight given to each rule and the sharp boundary that signals a breach of a specific rule. Another problem of this approach is that it does not consider natural and biological compounds. ROF excludes metabolic-related criteria.
Table 4 Physicochemical properties of compounds from T. aurea.
No |
Compound name |
Lipinski |
||||
MW |
MlogP ≤ 4.15 |
NorO ≤ 10 |
NHorOH ≤ 5 |
Violasi |
||
1 |
Morpholine, 2,6-dimethyl-4-tridecyl- |
297 |
3.85 |
2 |
0 |
Yes (0) |
2 |
Carbamic acid, monoammonium salt |
61 |
−6.14 |
2 |
2 |
Yes (0) |
3 |
Oxiranemethanol |
74 |
−1.03 |
2 |
1 |
Yes (0) |
4 |
Hexanal |
100 |
1.39 |
1 |
0 |
Yes (0) |
5 |
Heptanal |
114 |
1.74 |
1 |
0 |
Yes (0) |
6 |
Cyclohexanone, 2,2,6-trimethyl- |
140 |
2 |
1 |
0 |
Yes (0) |
7 |
2 octenal |
126 |
1.97 |
1 |
0 |
Yes (0) |
8 |
Cyclopentanone, 2-methyl-3-(1-methylethyl)- |
140 |
2 |
1 |
0 |
Yes (0) |
9 |
1-methylcycloheptanol |
128 |
1.83 |
1 |
1 |
Yes (0) |
10 |
1,2,3-propanetriol |
92 |
−1.51 |
3 |
3 |
Yes (0) |
11 |
2-decenal, (e)- |
154 |
2.59 |
1 |
0 |
Yes (0) |
12 |
6-methyl-6-nitro-2-heptanone |
173 |
0.59 |
3 |
0 |
Yes (0) |
13 |
Isosorbide |
146 |
−1.52 |
4 |
2 |
Yes (0) |
14 |
2-Benzofuranmethanol, 2,4,5,6,7,7a-hexahydro-4,4,7a-trimethyl-, cis- |
196 |
1.95 |
2 |
1 |
Yes (0) |
15 |
Phenol, 2,6-dimethoxy- |
154 |
0.87 |
3 |
1 |
Yes (0) |
16 |
8-hydroxygeraniol |
170 |
1.66 |
2 |
2 |
Yes (0) |
17 |
2(4H)-Benzofuranone, 5,6,7,7a-tetrahydro-4,4,7a-trimethyl- |
180 |
2.37 |
2 |
0 |
Yes (0) |
18 |
1,2,3,4-tetrahydroxybutane |
122 |
−1.91 |
4 |
4 |
Yes (0) |
19 |
Tetradecanoic acid |
228 |
3.69 |
2 |
1 |
Yes (0) |
20 |
Hexadecanoic acid, methyl ester |
270 |
4.44 |
2 |
0 |
Yes (1) |
21 |
Aphthosin |
646 |
2.83 |
13 |
4 |
No (2) |
22 |
Hexadecanoic acid |
256 |
4.19 |
2 |
1 |
Yes (1) |
Pharmacokinetics prediction
The pharmacokinetic evaluation of T. aurea compounds, shown in Table 5, reveals diverse absorption, distribution, and metabolic characteristics. HIA rates range from 51.7% to 97.5%, with most compounds exceeding 90%, indicating efficient gastrointestinal absorption. Caco-2 permeability values for all compounds are greater than 1, suggesting effective traversal of the intestinal epithelial barrier, a critical factor for oral bioavailability. Among the compounds, Morpholine, 2,6-dimethyl-4-tridecyl-, stands out as both a substrate and inhibitor of the CYP2D6 enzyme and interacts with the OCT2 transporter, hinting at potential metabolic and renal transport complexities. In contrast, most compounds, including Hexanal, Heptanal, and Cyclopentanone derivatives, do not exhibit CYP2D6 or OCT2 interactions, suggesting stable metabolic and renal profiles. Water solubility varies significantly, with compounds like Oxiranemethanol and 1,2,3-propanetriol demonstrating high solubility, supporting their absorption. Conversely, lipophilic compounds such as Hexadecanoic acid and its methyl ester exhibit poor solubility (log mol/L < −6), which may influence their bioavailability despite favorable absorption rates. BBB permeability analysis reveals that most compounds, such as Hexadecanoic acid and its methyl ester, possess moderate to high permeability (log BB values between 0.5 and 0.7), indicating their potential to reach the central nervous system (CNS). Compounds like Carbamic acid, monoammonium salt, show limited BBB penetration (log BB < 0), restricting their CNS access. These findings highlight the varied pharmacokinetic potential of T. aurea compounds, with most demonstrating effective gastrointestinal absorption, some capable of CNS permeation, and others maintaining metabolic stability. This diversity suggests promising applications for these compounds in pharmacological development.
Table 5 Pharmacokinetic characteristics of compounds from T. Aurea.
No |
Compound name |
Water solubility (log mol/L) |
Human intesntinal absorption (% Absorbed) |
Caco-2 permeability (log Papp in 10−6 cm/s) |
BBB permeability (log BB) |
CYP2D6 substrate |
CYP2D6 inhibitor |
OCT2 substrate |
1 |
Morpholine, 2,6-dimethyl-4-tridecyl- |
−5.802 |
89.774 |
1.48 |
0.864 |
Yes |
Yes |
Yes |
2 |
Carbamic acid, monoammonium salt |
−2.738 |
51.699 |
−0.359 |
−0.132 |
No |
No |
No |
3 |
Oxiranemethanol |
0.689 |
97.231 |
1.569 |
−0.255 |
No |
No |
No |
4 |
Hexanal |
−1.758 |
95.788 |
1.488 |
0.512 |
No |
No |
No |
5 |
Heptanal |
−2.406 |
95.432 |
1.487 |
0.546 |
No |
No |
No |
6 |
Cyclohexanone, 2,2,6-trimethyl- |
−2.122 |
96.981 |
1.508 |
0.267 |
No |
No |
No |
7 |
2 octenal |
−2.84 |
95.588 |
1.493 |
0.658 |
No |
No |
No |
8 |
Cyclopentanone, 2-methyl-3-(1-methylethyl)- |
−2.414 |
97.492 |
1.381 |
0.573 |
No |
No |
No |
9 |
1-methylcycloheptanol |
−1.308 |
93.941 |
1.472 |
0.162 |
No |
No |
No |
10 |
1,2,3-propanetriol |
0.881 |
74.246 |
1.073 |
−0.362 |
No |
No |
No |
11 |
2-decenal, (e)- |
−4.125 |
94.9 |
1.491 |
0.695 |
No |
No |
No |
12 |
6-methyl-6-nitro-2-heptanone |
−1.921 |
96.918 |
1.29 |
−0.195 |
No |
No |
No |
13 |
Isosorbide |
−0.916 |
86.251 |
1.056 |
−0.241 |
No |
No |
No |
14 |
2-Benzofuranmethanol, 2,4,5,6,7,7a-hexahydro-4,4,7a-trimethyl-, cis- |
−2.358 |
95.151 |
1.6 |
0.304 |
No |
No |
No |
15 |
Phenol, 2,6-dimethoxy- |
−1.4 |
93.789 |
1.734 |
−0.204 |
No |
No |
No |
16 |
8-hydroxygeraniol |
−1.168 |
92.334 |
1.511 |
−0.057 |
No |
No |
No |
17 |
2(4H)-Benzofuranone, 5,6,7,7a-tetrahydro-4,4,7a-trimethyl- |
−2.38 |
97.255 |
1.618 |
0.286 |
No |
No |
No |
18 |
1,2,3,4-tetrahydroxybutane |
−0.005 |
61.776 |
0.429 |
−0.983 |
No |
No |
No |
19 |
Tetradecanoic acid |
−4.952 |
92.691 |
1.56 |
−0.027 |
No |
No |
No |
20 |
Hexadecanoic acid, methyl ester |
−6.927 |
92.335 |
1.6 |
0.749 |
No |
No |
No |
21 |
Aphthosin |
−3.414 |
80.108 |
−0.133 |
−1.966 |
No |
No |
No |
22 |
Hexadecanoic acid |
−6.927 |
92.335 |
1.6 |
0.749 |
No |
No |
No |

Figure 4 Prediction of brain and intestinal permeability of nanoherbal T. aurea components using the BOILED-Egg predictive model. White regions indicate HIA (human intestinal absorption), while yellow regions represent BBB (blood-brain barrier) permeability. The molecular order corresponds to Table 4.
Based on Figure 4, the BOILED-Egg predictive model revealed the permeability potential of T. aurea components across the BBB and HIA. Molecules such as Morpholine, 2,6-dimethyl-4-tridecyl-, 2-decenal, E-, Tetradecanoic acid, and Hexadecanoic acid demonstrated strong BBB permeability due to their high lipophilicity and low TPSA values, making them promising candidates for central nervous system-targeted therapies. In contrast, molecules like Carbamic acid, monoammonium salt, 1,2,3-propanetriol, Isosorbide and 1,2,3,4-tetrahydroxybutane showed favorable intestinal absorption, indicating potential for oral bioavailability. Aphthosin exhibited limited permeability due to its high TPSA, restricting its transport across biological barriers. Meanwhile, molecules Heptanal, Cyclohexanone, 2,2,6-trimethyl-, Cyclopentanone, 2-methyl-3-(1-methylethyl)-, 1-methylcycloheptanol and Phenol, 2,6-dimethoxy- occupied regions near the BBB-HIA boundary, suggesting the need for further pharmacokinetic and bioavailability assessments to confirm their potential as therapeutic agents.
Toxicity prediction
The data presented in Table 6, provide a predictive toxicity profile of 22 compounds derived from T. aurea based on their LD50 values, predicted toxicity classes, and associated accuracy. Several compounds, such as Morpholine, 2,6-dimethyl-4-tridecyl- and Hexanal, fall into toxicity class 5, indicating they are “possibly hazardous” but are generally less toxic compared to compounds in lower toxicity classes. For instance, 1,2,3-propanetriol and Hexadecanoic acid, methyl ester also belongs to this class with relatively high LD50 values (4,090 - 5,000 mg/kg). Compounds like Carbamic acid, monoammonium salt, Oxiranemethanol, and Cyclohexanone, 2,2,6-trimethyl- are classified as toxicity class 4, indicating they are “harmful” if ingested, with LD50 values ranging from 420 to 958 mg/kg. These results suggest moderate acute toxicity. In contrast, Cyclopentanone, 2-methyl-3-(1-methylethyl)- and 2(4H)-Benzofuranone, 5,6,7,7a-tetrahydro-4,4,7a-trimethyl- are predicted to belong to toxicity class 2, indicating they are “fatal if swallowed” due to their very low LD50 values (25 and 34 mg/kg, respectively). These compounds pose a significantly higher risk of acute toxicity compared to others. Notably, 1-methylcycloheptanol and 1,2,3,4-tetrahydroxybutane are anticipated to exhibit low toxicity, with LD50 values of 7,200 and 23,000 mg/kg, respectively, categorizing them in toxicity class 6 (“non-toxic”). The prediction accuracy and similarity scores for most compounds are high, indicating reliable toxicity classifications. However, some compounds, such as 6-methyl-6-nitro-2-heptanone and Aphthosin, exhibit lower prediction accuracy (67.38% and 70.97%, respectively), which may warrant further experimental validation. This analysis highlights the diversity in toxicological profiles of compounds from T. aurea, ranging from non-toxic to highly toxic, emphasizing the importance of careful evaluation when considering their potential applications.
Table 6 Predicted toxicology levels of the compounds T. aurea.
No |
Compound name |
Predicted LD50 (mg/kg) |
Predicted toxicity class |
Average similarity |
Prediction accuracy |
1 |
Morpholine, 2,6-dimethyl-4-tridecyl- |
650 |
5 (possibly hazardous) |
100% |
100% |
2 |
Carbamic acid, monoammonium salt |
681 |
4 (harmful) |
100% |
100% |
3 |
Oxiranemethanol |
420 |
4 (harmful) |
100% |
100% |
4 |
Hexanal |
3,240 |
5 (possibly hazardous) |
100% |
100% |
5 |
Heptanal |
5,000 |
5 (possibly hazardous) |
100% |
100% |
6 |
Cyclohexanone, 2,2,6-trimethyl- |
500 |
4 (harmful) |
100% |
100% |
7 |
2 octenal |
5,000 |
5 (possibly hazardous) |
95.45% |
72.9% |
8 |
Cyclopentanone, 2-methyl-3-(1-methylethyl)- |
25 |
2 (fatal if swallowed) |
100% |
100% |
9 |
1-methylcycloheptanol |
7,200 |
6 (non-toxic) |
92.31% |
72.9% |
10 |
1,2,3-propanetriol |
4,090 |
5 (possibly hazardous) |
100% |
100% |
11 |
2-decenal, (e)- |
5,000 |
5 (possibly hazardous) |
100% |
100% |
12 |
6-methyl-6-nitro-2-heptanone |
958 |
4 (harmful) |
51.49% |
67.38% |
13 |
Isosorbide |
289 |
3 (toxic if swallowed) |
100% |
100% |
14 |
2-Benzofuranmethanol, 2,4,5,6,7,7a-hexahydro-4,4,7a-trimethyl-, cis- |
4,300 |
5 (possibly hazardous) |
67.34% |
68.07% |
15 |
Phenol, 2,6-dimethoxy- |
550 |
4 (harmful) |
100% |
100% |
16 |
8-hydroxygeraniol |
2,100 |
5 (possibly hazardous) |
95.45% |
72.9% |
17 |
2(4H)-Benzofuranone, 5,6,7,7a-tetrahydro-4,4,7a-trimethyl- |
34 |
2 (fatal if swallowed) |
85.4% |
70.97% |
18 |
1,2,3,4-tetrahydroxybutane |
23,000 |
6 (non-toxic) |
100% |
100% |
19 |
Tetradecanoic acid |
900 |
4 (harmful) |
100% |
100% |
20 |
Hexadecanoic acid, methyl ester |
5,000 |
5 (possibly hazardous) |
100% |
100% |
21 |
Aphthosin |
962 |
4 (harmful) |
82.15% |
70.97% |
22 |
Hexadecanoic acid |
900 |
4 (harmful) |
100% |
100% |
The data presented in Table 7 provide a predictive organ toxicity profile of 22 compounds derived from T. aurea. Most compounds are predicted to cross the blood-brain barrier (BBB), as indicated by their “Active” status for this parameter. However, their potential toxicity to other organs, including the liver, kidneys, heart, and immune system, is largely minimal. For instance, compounds such as Hexanal, Heptanal, and 2-decenal (E)- are active in crossing the BBB but show no significant toxicity to other organs, suggesting their safety profile in terms of organ-specific toxicity. Similarly, Cyclopentanone, 2-methyl-3-(1-methylethyl)- is active in crossing the BBB without displaying hepatotoxicity, nephrotoxicity, cardiotoxicity, or immunotoxicity. Conversely, Oxiranemethanol and 6-methyl-6-nitro-2-heptanone demonstrate potential neurotoxicity and mutagenicity, respectively, despite their inactive status in causing hepatotoxicity and nephrotoxicity. Such findings highlight their potential risks despite limited toxicity in other areas. Compounds like Phenol, 2,6-dimethoxy- and Aphthosin are noteworthy for their nephrotoxicity while being inactive across other toxicity categories. These findings underscore the importance of evaluating kidney-specific effects in applications involving these compounds. Interestingly, 1,2,3,4-tetrahydroxybutane, a compound predicted to be non-toxic in Table 7, demonstrates potential nephrotoxicity and cardiotoxicity, suggesting that even compounds classified as “non-toxic” based on LD50 values might pose risks to specific organs. Overall, this analysis highlights the variability in toxicity profiles among T. aurea compounds, with a focus on their ability to cross the BBB and the potential risks to vital organs, underscoring the need for careful evaluation in therapeutic applications.
Table 7 Predicted organ toxicity of the compounds T. aurea.
No |
Compound name |
Organ toxicity |
||||||
Hepato toxicity |
Neurot oxicity |
Nephrot oxicity |
Cardio toxicity |
BBB barrier |
Immuno toxicity |
Mutageni city |
||
1 |
Morpholine, 2,6-dimethyl-4-tridecyl- |
Inactive |
Active |
Inactive |
Inactive |
Active |
Inactive |
Inactive |
2 |
Carbamic acid, monoammonium salt |
Inactive |
Inactive |
Inactive |
Inactive |
Active |
Inactive |
Inactive |
3 |
Oxiranemethanol |
Inactive |
Inactive |
Inactive |
Active |
Active |
Inactive |
Active |
4 |
Hexanal |
Inactive |
Inactive |
Inactive |
Inactive |
Active |
Inactive |
Inactive |
5 |
Heptanal |
Inactive |
Inactive |
Inactive |
Inactive |
Active |
Inactive |
Inactive |
6 |
Cyclohexanone, 2,2,6-trimethyl- |
Inactive |
Active |
Inactive |
Inactive |
Active |
Inactive |
Inactive |
7 |
2 octenal |
Inactive |
Inactive |
Inactive |
Inactive |
Active |
Inactive |
Inactive |
8 |
Cyclopentanone, 2-methyl-3-(1-methylethyl)- |
Inactive |
Inactive |
Inactive |
Inactive |
Active |
Inactive |
Inactive |
9 |
1-methylcycloheptanol |
Inactive |
Inactive |
Inactive |
Inactive |
Active |
Inactive |
Inactive |
10 |
1,2,3-propanetriol |
Inactive |
Inactive |
Active |
Active |
Inactive |
Inactive |
Inactive |
11 |
2-decenal, (e)- |
Inactive |
Inactive |
Inactive |
Inactive |
Active |
Inactive |
Inactive |
12 |
6-methyl-6-nitro-2-heptanone |
Inactive |
Inactive |
Inactive |
Inactive |
Active |
Inactive |
Active |
13 |
Isosorbide |
Inactive |
Inactive |
Inactive |
Active |
Active |
Inactive |
Inactive |
14 |
2-Benzofuranmethanol, 2,4,5,6,7,7a-hexahydro-4,4,7a-trimethyl-, cis- |
Inactive |
Inactive |
Inactive |
Inactive |
Active |
Inactive |
Inactive |
15 |
Phenol, 2,6-dimethoxy- |
Inactive |
Inactive |
Active |
Inactive |
Active |
Inactive |
Inactive |
16 |
8-hydroxygeraniol |
Inactive |
Inactive |
Inactive |
Inactive |
Active |
Inactive |
Inactive |
17 |
2(4H)-Benzofuranone, 5,6,7,7a-tetrahydro-4,4,7a-trimethyl- |
Inactive |
Inactive |
Inactive |
Inactive |
Active |
Inactive |
Inactive |
18 |
1,2,3,4-tetrahydroxybutane |
Inactive |
Inactive |
Active |
Active |
Inactive |
Inactive |
Inactive |
19 |
Tetradecanoic acid |
Inactive |
Inactive |
Inactive |
Inactive |
Active |
Inactive |
Inactive |
20 |
Hexadecanoic acid, methyl ester |
Inactive |
Inactive |
Inactive |
Inactive |
Active |
Inactive |
Inactive |
21 |
Aphthosin |
Inactive |
Inactive |
Active |
Inactive |
Active |
Inactive |
Inactive |
22 |
Hexadecanoic acid |
Inactive |
Inactive |
Inactive |
Inactive |
Active |
Inactive |
Inactive |
Molecular interactions of T. aurea compounds with 6KZZ protein
Twenty-three bioactive compounds from T. aurea were evaluated for their binding potential with the 6KZZ protein through molecular docking studies (Table 8), revealing diverse affinities that highlight their potential for antimicrobial applications. Aphthosin exhibits the greatest binding affinity among the evaluated compounds, with a binding energy of −7.4 kcal/mol, exceeding that of the control. It forms hydrogen bonds with HIS 55, ARG 76, and THR 163, while also exhibiting significant hydrophobic interactions with ILE 60 and LYS 162, indicating its relatively strong potential as an antimicrobial agent. The control compound, 4-[[8-(methylamino)-2-oxidanylidene-1H-quinolin-3-yl]carbonylamino]benzoic acid, demonstrated a robust binding energy of −6.2 kcal/mol. It interacts with residues HIS 55, ASP 74, and ARG 136 through hydrogen bonds, while also engaging with THR 163 via hydrophobic interactions. This suggests a robust interaction profile, enhancing its biological efficacy. The 3-dimensional interactions between the ligands and the 6KZZ protein are depicted in Figures 5 and 6, further supporting their binding profiles.
Table 8 Residue and biding energy of ligand and 6KZZ interaction.
No |
Ligands |
Interaction Type |
Binding Afinity |
||||
Hydrogen Bond |
Hydrophobic |
Electrostatis |
Unfavorable |
||||
Hydrogen Bond |
Carbon Hydrogen Bond |
||||||
Control |
|||||||
1 |
4-[[8-(methylamino)-2-oxidanylidene-1~{H}-quinolin-3-yl]carbonylamino]benzoic acid9 (Control) |
HIS 55, ASP 74, ARG 136 |
THR 163 |
LYS 57, ARG 76 |
- |
- |
−6.2 |
Bioactive components of the T. aurea |
|||||||
1 |
Morpholine, 2,6-dimethyl-4-tridecyl- |
- |
- |
ILE 60, LYS 162, ARG 204, HIS 215 |
- |
- |
−4.3 |
2 |
GLN 135, THR 163 |
GLY 164 |
- |
- |
GLN 72 |
−2.8 |
|
3 |
Oxiranemethanol |
THR 62, SER 70 |
|
- |
- |
- |
−2.9 |
4 |
Hexanal |
ARG 76 |
- |
- |
- |
- |
−3.0 |
5 |
Heptanal |
ARG 76 |
|
|
- |
- |
−4.2 |
6 |
Cyclohexanone, 2,2,6-trimethyl- |
THR 62, SER 70 |
- |
ILE 60, MET 166, LYS 208 |
- |
- |
−3.5 |
7 |
2 octenal |
THR 163 |
- |
ILE 60, LYS 162 |
- |
- |
−4.1 |
8 |
Cyclopentanone, 2-methyl-3-(1-methylethyl)- |
|
- |
- |
- |
- |
−4.1 |
9 |
1-methylcycloheptanol |
GLN 135 |
- |
LYS 162 |
- |
- |
−4.1 |
10 |
ASP 49, GLU 50 |
ASN 46 |
- |
- |
- |
−3.3 |
|
11 |
THR 163 |
- |
ILE 60, LYS 162 |
- |
- |
−3.6 |
|
12 |
6-methyl-6-nitro-2-heptanone |
THR 62, SER 70, ARG 206, LYS 208 |
- |
- |
- |
- |
−4.2 |
13 |
THR 62, SER 70 |
- |
- |
- |
- |
−4.0 |
|
14 |
2-Benzofuranmethanol, 2,4,5,6,7,7a-hexahydro-4,4,7a-trimethyl-, cis- |
ASP 73 |
- |
LYS 162 |
- |
GLN 72 |
−4.8 |
15 |
Phenol, 2,6-dimethoxy- |
THR 62, SER 70 |
- |
ILE 60, HIS 64, MET 166 |
- |
- |
−4.2 |
16 |
8-hydroxygeraniol |
GLY 75, THR 163 |
- |
HIS 55, ARG 76, ARG 136 |
- |
- |
−4.4 |
17 |
GLU 50 |
- |
ILE 94 |
- |
- |
−4.9 |
|
18 |
1,2,3,4-tetrahydroxybutane |
ASN 46, ASP 49, ARG 76 |
- |
- |
- |
GLU 50 |
−3.9 |
19 |
ARG 204 |
- |
ILE 60, LYS 162 |
- |
- |
−4.0 |
|
20 |
Hexadecanoic acid, methyl ester |
ARG 204 |
- |
ILE 60, LYS 162 |
- |
- |
−4.2 |
21 |
Aphthosin |
HIS 55, ARG 76, THR 163 |
GLU 58 |
ILE 60, LYS 162 |
- |
ASP 74 |
−7.4 |
22 |
Hexadecanoic acid |
ARG 204, ARG 206 |
- |
LYS 162 |
- |
- |
−4.2 |
In contrast, numerous compounds demonstrate diminished binding affinities. The carbamic acid monoammonium salt exhibits a binding energy of −2.8 kcal/mol, forming hydrogen bonds with GLN 135 and THR 163, while lacking significant hydrophobic or electrostatic interactions. Similarly, hexanal, with a binding energy of −3.0 kcal/mol, interacts weakly with ARG 76, reflecting its limited potential in terms of biological activity. Additional compounds, including 1,2,3-propanetriol and 2-decenal, exhibit reduced binding energies of −3.3 and −3.6 kcal/mol, respectively. Their interactions are primarily based on hydrogen bonds, with minimal hydrophobic or electrostatic engagement, suggesting that these compounds may require further optimization to enhance their binding affinities and antimicrobial potential. Overall, this analysis underscores the varied interaction profiles of the bioactive compounds from T. aurea, highlighting both high-affinity candidates for further development and those that may benefit from structural modifications to improve their biological activity.
Protein 6KZZ, also known as E. coli DNA Gyrase B, is a critical enzyme in bacterial DNA replication, transcription, and repair. It is important for inserting negative supercoils into DNA to release tension during strand unwinding DNA Gyrase B is essential in the ATP-dependent strand passing mechanism, and inhibitors that target this subunit can decrease its function by attaching to the ATP-binding domain, inhibiting ATP hydrolysis and disrupting the supercoiling process. Because of its interference with DNA replication, DNA Gyrase B is an important target for antimicrobial medicines, particularly those focused at tackling resistant bacterial strains [13,27].
The agreement between the in vitro antibacterial activity of T. aurea extract particularly its inhibition of S. aureus and S. Typhii and the in silico docking results, where Aphthosin exhibited the most favorable binding affinity to DNA gyrase (6KZZ), suggests a potential relationship between experimental and computational findings. These results indicate that bioactive compounds from T. aurea may serve as promising candidates for further investigation as natural antibacterial agents targeting bacterial DNA gyrase.

Figure 5 3D interactions of 4-[[8-(methylamino)-2-oxidanylidene-1~{H}-quinolin-3-yl]carbonylamino]benzoic acid9 and bioactive compounds from T. aurea (Linnaeus) C.Martius against the 6KZZ protein. (A) 4-[[8-(methylamino)-2-oxidanylidene-1~{H}-quinolin-3-yl]carbonylamino]benzoic acid9; (B) Morpholine, 2,6-dimethyl-4-tridecyl-, (z)-; (C) Carbamic acid, monoammonium salt; (D) Oxiranemethanol; (E) Hexanal; (F) Heptanal; (G) Cyclohexanone, 2,2,6-trimethyl-; (H) Cyclohexanol, 3,5-dimethyl-; (I) 2 octenal; (J) Cyclopentanone, 2-methyl-3-(1-methylethyl)-; (K) 1-methylcycloheptanol; (L) 1,2,3-propanetriol; (M) 2-decenal, (e)-; 6-methyl-6-nitro-2-heptanone; (O) Isosorbide; (P) 2-Benzofuranmethanol, 2,4,5,6,7,7a-hexahydro-4,4,7a-trimethyl-, cis-; (Q) Phenol, 2,6-dimethoxy; (R) 8-hydroxygeraniol; (S) 2(4H)-Benzofuranone, 5,6,7,7a-tetrahydro-4,4,7a-trimethyl-; (T) 1,2,3,4-tetrahydroxybutane; (U) Tetradecanoic acid (V) Hexadecanoic acid, methyl ester (X) Aphthosin; (Y) Hexadecanoic acid.

Figure 6 2D interactions of 4-[[8-(methylamino)-2-oxidanylidene-1~{H}-quinolin-3-yl]carbonylamino]benzoic acid9 (Control) and bioactive compounds from T. aurea (Linnaeus) C.Martius against the 6KZZ protein. (A) 4-[[8-(methylamino)-2-oxidanylidene-1~{H}-quinolin-3-yl]carbonylamino]benzoic acid9; (B) Morpholine, 2,6-dimethyl-4-tridecyl-, (z)-; (C) Carbamic acid, monoammonium salt; (D) Oxiranemethanol; (E) Hexanal; (F) Heptanal; (G) Cyclohexanone, 2,2,6-trimethyl-; (H) Cyclohexanol, 3,5-dimethyl-; (I) 2 octenal; (J) Cyclopentanone, 2-methyl-3-(1-methylethyl)-; (K) 1-methylcycloheptanol; (L) 1,2,3-propanetriol; (M) 2-decenal, (e)-; 6-methyl-6-nitro-2-heptanone; (O) Isosorbide; (P) 2-Benzofuranmethanol, 2,4,5,6,7,7a-hexahydro-4,4,7a-trimethyl-, cis-; (Q) Phenol, 2,6-dimethoxy; (R) 8-hydroxygeraniol; (S) 2(4H)-Benzofuranone, 5,6,7,7a-tetrahydro-4,4,7a-trimethyl-; (T) 1,2,3,4-tetrahydroxybutane; (U) Tetradecanoic acid (V) Hexadecanoic acid, methyl ester (X) Aphthosin; (Y) Hexadecanoic acid.
Conclusions
This study demonstrates that Trentepohlia aurea possesses antibacterial potential, particularly against Gram-positive bacteria, and contains multiple bioactive constituents as revealed by GC-MS analysis. Among these, Aphthosin emerged as a promising candidate in molecular docking studies, showing strong predicted affinity for bacterial DNA gyrase (6KZZ). While these findings suggest a possible mechanism of action and support the value of T. aurea as a source of natural antibacterial agents, they remain preliminary. The absence of compound isolation, direct antibacterial testing of individual constituents, and determination of MIC or MBC limits the strength of causal inferences about Aphthosin’s role. Future studies should incorporate targeted purification, in vitro validation of key compounds, and comprehensive pharmacological profiling to confirm activity and safety. Such work could pave the way for the development of novel antibacterial agents derived from this underexplored algal species.
Acknowledgements
This work was supported by Ministry of Education, Culture, Research, and Technology, Republic of Indonesia under of PMDSU Research Grant (Contract Number: 76/UN5.4.10.K/PT.01.03/KP-DPPM/2025).
Declaration of Generative AI in Scientific Writing
No generative AI tools were used in the writing of this manuscript.
CRediT Author Statement
Oky Kusuma Atni: Investigation, Methodology, Research data collection, Data analysis, and Writing original draft. Erman Munir: Conceptualization, Investigation, Reviewing and editing, and Corresponding author. Nursahara Pasaribu: Research design, Project administration, Writing reviewing, Data curation, and Editing.
References
MM El-Sheekh, N Abdullah and I Ahmad. Handbook of research on algae as a sustainable solution for food, energy, and the environment. IGI Global, Pennsylvania, 2022.
P Mallick and S Chatterjee. Textbook of algae. Techsar, New Delhi, India, 2024.
TNBT Ibrahim, NAS Feisal, NH Kamaludin, WY Cheah, V How, A Bhatnagar and PL Show. Biological active metabolites from microalgae for healthcare and pharmaceutical industries: A comprehensive review. Bioresource Technology 2023; 372, 12866.
L Chen, L Zhang and T Liu. Concurrent production of carotenoids and lipid by a filamentous microalga Trentepohlia arborum. Bioresource Technology 2016; 214, 567-573.
V Dolganyuk, D Belova, O Babich, A Prosekov, S Ivanova, D Katserov and S Sukhikh. Microalgae: A promising source of valuable bioproducts. Biomolecules 2020; 10(8), 1153.
N Mishra, E Gupta, P Singh and R Prasad. Application of microalgae metabolites in food and pharmaceutical industry. In: C Egbuna, AP Mishra and MR Goyal (Eds.). Preparation of phytopharmaceuticals for the management of disorders. Academic Press, London, 2023, p. 391-408.
H Upadhyay, L Saini and A Chakraborty. Trentepohlia. In: N Amaresan and K Kumar (Eds.). Compendium of phytopathogenic microbes in agro-ecology: Bacteria, protozoa, algae and nematodes. Springer Nature, Cham, Switzerland, 2025, p. 681-701.
S Saraphol, S Vajrodaya, E Kraichak, A Sirikhachornkit and N Sanevas. Environmental factors affecting the diversity and photosynthetic pigments of trentepohlia species in Northern Thailand’s chiang dao wildlife sanctuary. Acta Societatis Botanicorum Poloniae 2020; 89(1), 1-24.
R Kant, K Sarma, N Kumar, M Sharma, NC Halder, A Tyagi, D Gupta and V Malik. Biochemical profiling of chlorophylls, carotenoids, proteins and lipids of Trentepohlia aurea (l) c. Martius, Chlorophyta. Egyptian Journal of Phycology 2024; 25(1), 15-20.
D Zhang, M Wan, EA del Rio-Chanona, J Huang, W Wang and Y Li. Vassiliadis vs. dynamic modelling of Haematococcus pluvialis photoinduction for astaxanthin production in both attached and suspended photobioreactors. Algal Research 2016; 13, 69-78.
D Kharkongor and P Ramanujam. Antioxidant activities of 4 dominant species of Trentepohlia (Trentepohliales, Chlorophyta). International Journal of Complementary and Alternative Medicine 2017; 8(5), 00270.
E Sanniyasi and PP Raj. Accumulation of antioxidant pigment canthaxanthin (Β, Β-carotene-4, 4’-dione) from an aero-terrestrial, filamentous green microalga Trentepohlia Sp. Bioresource Technology Reports 2024; 25, 101803.
F Ushiyama, H Amada, T Takeuchi, N Tanaka-Yamamoto, H Kanazawa, K Nakano and N Ohtake. Lead identification of 8-(methylamino)-2-oxo-1, 2-dihydroquinoline derivatives as DNA gyrase inhibitors: Hit-to-lead generation involving thermodynamic evaluation. ACS Omega 2020; 5(17), 10145-10159.
S Ruan, T Chih-Han and CR Bourne. Friend or foe: Protein inhibitors of DNA gyrase. Biology 2024; 13(2), 84.
M Salman, P Sharma, M Kumar, AS Ethayathulla and P Kaur. Targeting novel sites in DNA gyrase for development of anti-microbials. Briefings in Functional Genomics 2023; 22(2), 180-194.
GS Bisacchi and JI Manchester. A new-class antibacterial almost. Lessons in drug discovery and development: A critical analysis of more than 50 years of effort toward ATPase inhibitors of DNA gyrase and topoisomerase IV. ACS Infectious Diseases 2025; 1(1), 4-41.
J Hudzicki. Kirby-Bauer disk diffusion susceptibility test protocol. American Society for Microbiology 2019; 15(1), 1-23.
OK Atni, E Munir and N Pasaribu. Diversity of bioactive compounds from Parmotrema xanthinum as antimicrobial potential through in-vitro and in-silico assessment. Biodiversitas Journal of Biological Diversity 2024; 25(11), 4438-4449.
OK Atni, E Munir and N Pasaribu. In-vitro and in-silico study of bioactive compounds from Coccocarpia erythroxyli as inhibitors targeting PBP3 (6ILE) for antibacterial applications. Trends in Sciences 2025; 22(8), 10291.
S Simic, M Kosanic and B Rankovic. Evaluation of in vitro antioxidant and antimicrobial activities of green microalgae Trentepohlia umbrina. Notulae Botanicae Horti Agrobotanici Cluj-Napoca 2012; 40(2), 86-91.
RM Epand, C Walker, RF Epand and NA Magarvey. Molecular mechanisms of membrane targeting antibiotics. Biochimica et Biophysica Acta (BBA)-Biomembranes 2016; 1858(5), 980-987.
MP Mingeot-Leclercq and JL Décout. Bacterial lipid membranes as promising targets to fight antimicrobial resistance, molecular foundations and illustration through the renewal of aminoglycoside antibiotics and emergence of amphiphilic aminoglycosides. MedChemComm 2016; 7(4), 586-611.
K Chekanov. Diversity and distribution of carotenogenic algae in Europe: A review. Marine Drugs 2023; 21(2), 108.
BA Jaber, KR Majeed and AG Al Hashimi. Antioxidant and antibacterial activity of β-carotene pigment extracted from Paracoccus homiensis strain bka7 isolated from Air of Basra, Iraq. Annals of the Romanian Society for Cell Biology 2021; 25(4), 14006-14027.
CA Lipinski, F Lombardo, BW Dominy and PJ Feeney. Experimental and computational approaches to estimate solubility and permeability in drug discovery and development settings. Advanced Drug Delivery Reviews1997; 23(1-3), 3-25.
G Petit, C Kornreich, X Noel, P Verbanck and S Campanella. Alcohol-related context modulates performance of social drinkers in a visual Go/No-Go task: A preliminary assessment of event-related potentials. Plos One 2012; 7(5), e37466.
K Rajakumari, K Aravind, M Balamugundhan, M Jagadeesan, A Somasundaram, P Devi and P Ramasamy. Comprehensive review of DNA gyrase as enzymatic target for drug discovery and development. European Journal of Medicinal Chemistry Reports 2024; 12, 100233.